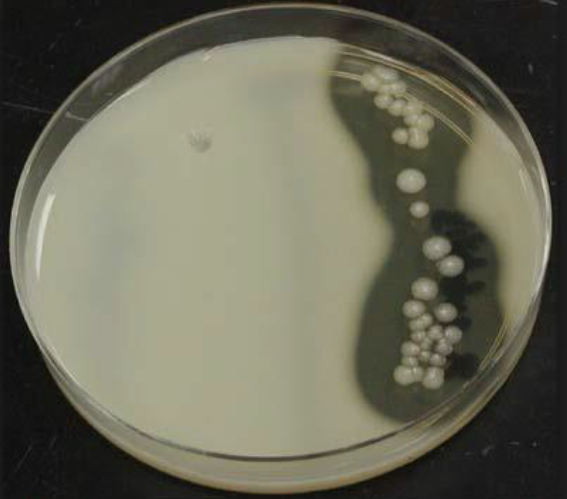
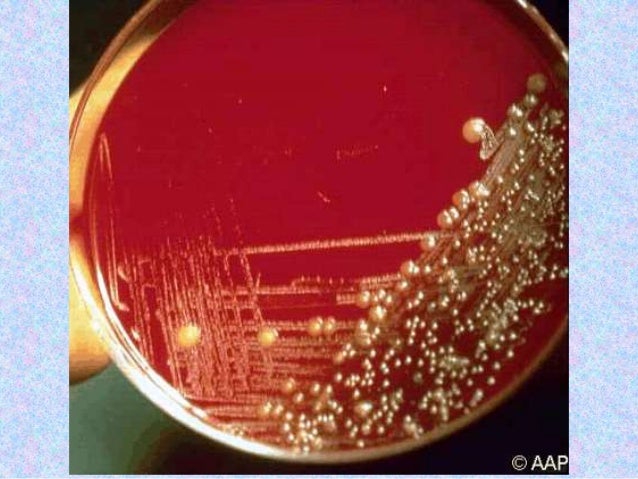
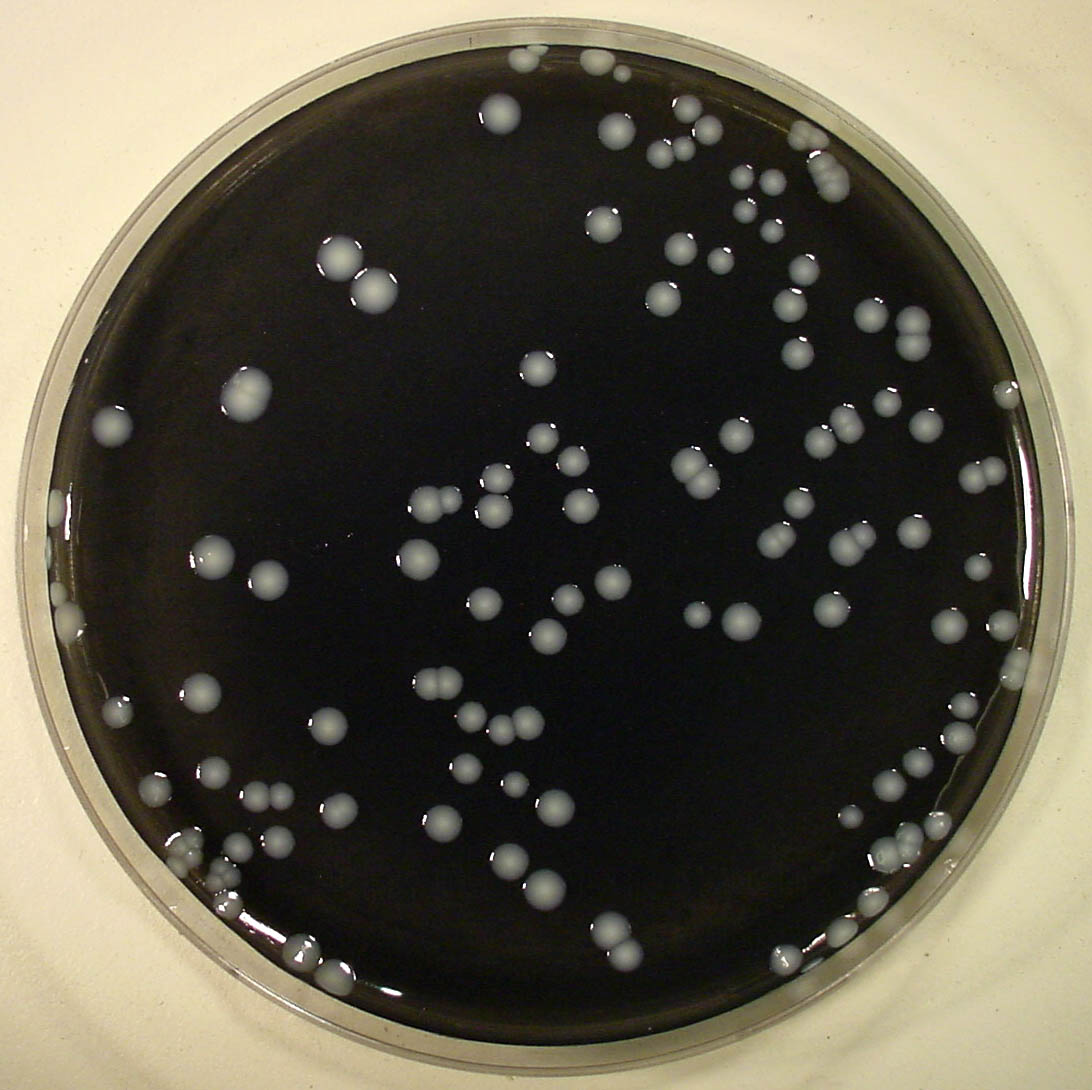
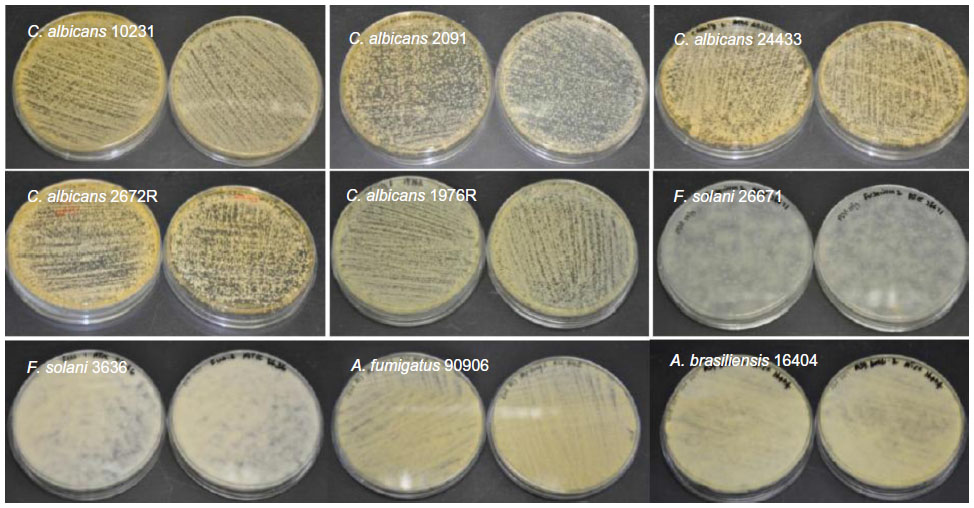

Казеиновый агар
Казеиновый агар 143 фото
Какое масло лить в форд фьюжн
Клипса после операции
Отбивание мяча в теннисе
Шутки радио читать
Фора 5.5 что значит
Первый поход в клуб
Сборный пункт краснодар
Диетические рецепты на скорую руку
Йоркшир гризодубовой
Южный парк закрывают